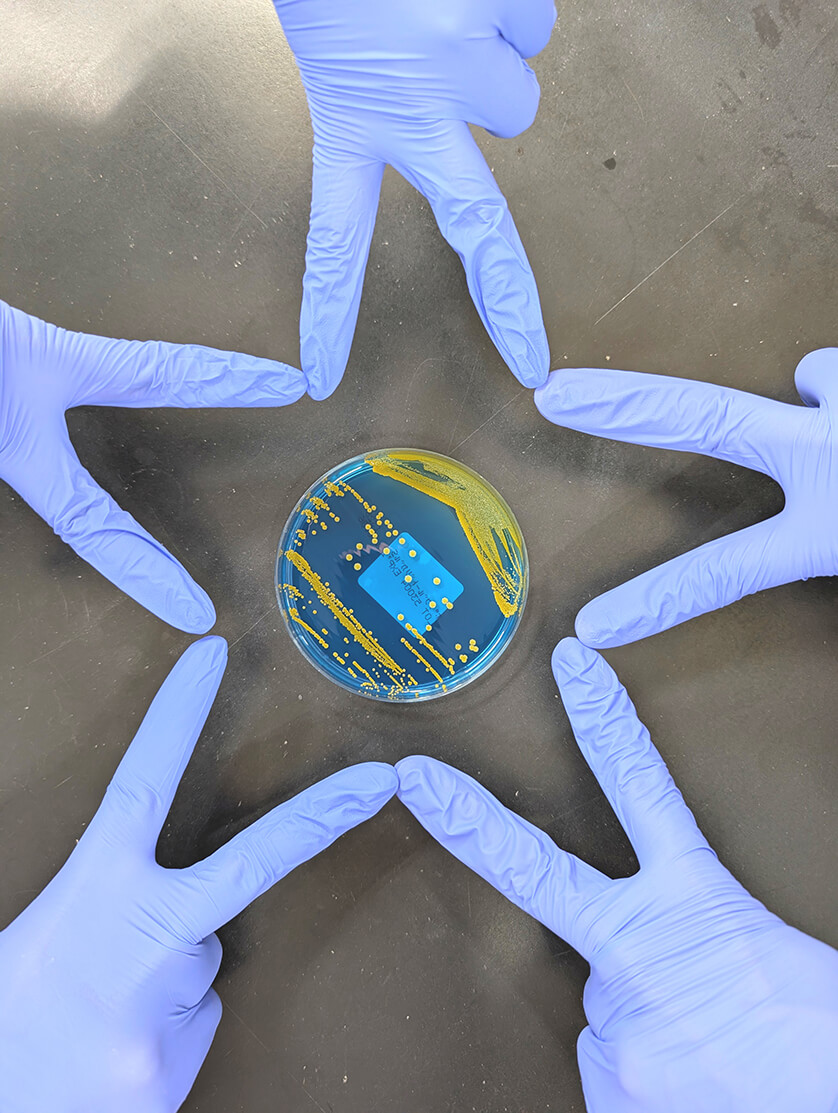

施設情報[病院・クリニック・研究所]
埼玉県
 上尾中央総合病院
上尾中央総合病院
| 職員構成 | 合計109名(男性23名 女性86名) |
|---|---|
| 当直体制 | 当直 |
| 病理検査室の有無 | あり |
| 職場の雰囲気 | 検査数も多く忙しい毎日ですが、その分多くの症例を学ぶことのできる職場です。 教育体制が整っており若手を中心に切磋琢磨しながら大きく成長していける活気に溢れた環境です。 |




施設見学に関して
イインターンシップ開催:6月~7月に実施します。詳しくは病院ホームページをご参照下さい。
 八潮中央総合病院
八潮中央総合病院
| 職員構成 | 合計20名(男性5名 女性15名) |
|---|---|
| 当直体制 | 当直 |
| 病理検査室の有無 | なし |
| 職場の雰囲気 | 様々な学会や研修会に参加できる環境下であり、自己研鑽に励める職場です。 お子さんを育てながら働いているスタッフもおり、アットホームな検査室です。 |




施設見学に関して
随時見学可能です。総務課人事担当者へご連絡お願いします。
 吉川中央総合病院
吉川中央総合病院
| 職員構成 | 合計18名(男性5名 女性13名) |
|---|---|
| 当直体制 | 当直 |
| 病理検査室の有無 | なし |
| 職場の雰囲気 | 明るい雰囲気の職場で、活気のある検査室です。 子育てしながら働いている職員も数多くいます。 |




施設見学に関して
随時可能です。総務課人事担当者へご連絡ください。
 白岡中央総合病院
白岡中央総合病院
| 職員構成 | 合計18名(男性3名 女性15名) |
|---|---|
| 当直体制 | 当直 |
| 病理検査室の有無 | なし |
| 職場の雰囲気 | 検査も笑顔も全員でシェア! 業務を分担しつつ、笑顔とチームワークで真剣に検査に向き合います! |




施設見学に関して
病院ホームページより随時お申込みいただけます。2027年度に当院は新築移転予定です!
 東川口病院
東川口病院
| 職員構成 | 合計17名(男性4名 女性13名) |
|---|---|
| 当直体制 | 当直 |
| 病理検査室の有無 | なし |
| 職場の雰囲気 | 幅広い年齢層で構成された、優しい雰囲気の検査室です。それぞれが目標を持ち達成にむけてコツコツと経験を積んでいます。 |




施設見学に関して
随時受け付けています。総務課人事課にお問い合わせください。
 彩の国東大宮メディカルセンター
彩の国東大宮メディカルセンター
| 職員構成 | 合計39名(男性8名 女性31名) |
|---|---|
| 当直体制 | 当直+オンコール |
| 病理検査室の有無 | 有り |
| 職場の雰囲気 | 多忙な時間帯は担当セクションを超えて、業務をサポートする環境です。日頃から、思いやりを持ち協力し合っています。また、資格取得や学会発表等自己啓発に努める事ができる職場です。 |




施設見学に関して
見学をご希望の際は、病院ホームページよりお問い合わせください。
 三郷中央総合病院
三郷中央総合病院
| 職員構成 | 合計25名(男性5名 女性20名) |
|---|---|
| 当直体制 | 当直 |
| 病理検査室の有無 | なし |
| 職場の雰囲気 | 臨床側から求められるものは多岐にわたりますが、困ったことは助け合いながら、切磋琢磨しながら、成長できる職場です! |




施設見学に関して
随時見学可能です。詳しくは病院ホームページ(採用情報)をご覧ください。
 越谷誠和病院
越谷誠和病院
| 職員構成 | 合計12名(男性3名 女性9名) |
|---|---|
| 当直体制 | 当直 |
| 病理検査室の有無 | なし |
| 職場の雰囲気 | 全員で教え合い、支え合い、成長を実感できる検査室です。他職種との連携、合同研修会、合同学術発表なども行っています。 |




施設見学に関して
随時見学可能です。ご希望の際は病院ホームページからお問い合わせ下さい。
 伊奈病院
伊奈病院
| 職員構成 | 職員構成 合計22名(男性2名 女性20名) |
|---|---|
| 当直体制 | 当直 |
| 病理検査室の有無 | なし |
| 職場の雰囲気 | ステップアップに前向きな取り組みができます!広い範囲での業務に対応しながら多様な学びに出会い、仲間と協力する喜びがある職場です。 |




施設見学に関して
随時見学可能です。ご希望の際は病院ホームページからお問い合わせ下さい。
 上尾中央第ニ病院
上尾中央第ニ病院
| 職員構成 | 合計3名(女性3名) |
|---|---|
| 当直体制 | なし |
| 病理検査室の有無 | なし |
| 職場の雰囲気 | 慢性期の病院であるため院内測定は少なく、入院患者の検査よりも健診や人間ドック、透析関連の生理機能検査が主です。 |



施設見学に関して
見学は可能。
 蓮田一心会病院
蓮田一心会病院
| 職員構成 | 合計9名(男性3名 女性6名) |
|---|---|
| 当直体制 | オンコール |
| 病理検査室の有無 | なし |
| 職場の雰囲気 | 笑顔のあふれる職場です。小規模ならではの、多職種が顔をつき合わせた関係で、基本的にはすべての検査業務を全員がこなしていきます。 |




施設見学に関して
採用募集時は随時見学可能です。ご希望の際は病院人事担当までお問い合わせください。
 メディカルトピア草加病院
メディカルトピア草加病院
| 職員構成 | 合計23名(男性1名 女性22名) |
|---|---|
| 当直体制 | オンコール |
| 病理検査室の有無 | なし |
| 職場の雰囲気 | 「態度・進取・仲間」というプリンシプルにのっとり、人間性の向上にたえず努力することをモットーとしています。 |




施設見学に関して
ご希望の際は病院ホームページからお問い合わせ下さい。
 埼玉回生病院
埼玉回生病院
| 職員構成 | 合計4名(男性1名 女性3名) |
|---|---|
| 当直体制 | なし |
| 病理検査室の有無 | なし |
| 職場の雰囲気 | 少人数でオールラウンドに検査を担当し、お互いに助け合い業務を行っています。次々と依頼される検査をテキパキとこなしながらも、穏やかな人ばかりの職場です。 |




施設見学に関して
随時見学可能です。ご希望の際は病院ホームページからお問い合わせ下さい。
 上尾中央総合病院付属 エイトナインクリニック
上尾中央総合病院付属 エイトナインクリニック
| 職員構成 | 職員構成 合計2名(女性2名) |
|---|---|
| 当直体制 | なし |
| 病理検査室の有無 | なし |
| 職場の雰囲気 | アットホームな雰囲気の職場です。業務は超音波検査など生理検査が中心です |



施設見学に関して
見学可能です
 アルシェクリニック
アルシェクリニック
| 職員構成 | 合計12名(男性0名 女性12名) |
|---|---|
| 当直体制 | なし |
| 病理検査室の有無 | なし |
| 職場の雰囲気 | 健診センターが主体で活気のある施設です。超音波検査が主業務で、健診では6台装置を使用し、皆で協力しあいながら検査を行っています。資格取得にも積極的に取り組んでいます。 |




施設見学に関して
随時見学可能です。ご希望の際は病院ホームページからお問い合わせ下さい。
 上尾中央腎クリニック
上尾中央腎クリニック
| 職員構成 | 合計1名(男性1名) |
|---|---|
| 当直体制 | なし |
| 病理検査室の有無 | なし |
| 職場の雰囲気 | 透析専門のクリニックです。看護師、臨床工学技士 とコミュニケーションを密に取り、検査業務を行っています。 |


施設見学に関して
随時見学可能です。ご希望の際はクリニックホームページからお問い合わせ下さい。
 桶川腎クリニック
桶川腎クリニック
| 職員構成 | 合計1名(女性1名) |
|---|---|
| 当直体制 | なし |
| 病理検査室の有無 | なし |
| 職場の雰囲気 | 透析室の中の検査室をモットーに、技師1名で他部署と交わりながら、検査業務を行っています。患者さんと近くて長いお付き合いの中で、寄り添った検査を心がけています。 |




施設見学に関して
随時見学可能です。ご希望の際はお電話にてお問い合わせください。
 西大宮腎クリニック
西大宮腎クリニック
| 職員構成 | 合計1名(女性1名) |
|---|---|
| 当直体制 | なし |
| 病理検査室の有無 | なし |
| 職場の雰囲気 | 一人部署ですがチーム医療の一員として他スタッフと常に情報共有し患者様との関わりの多い職場です。 |


施設見学に関して
随時見学可能です。ご希望の際は病院ホームページからお問い合わせ下さい。
 株式会社アムル
株式会社アムル
| 職員構成 | 合計99名(男性33名 女性66名) |
|---|---|
| 当直体制 | なし |
| 病理検査室の有無 | あり |
| 職場の雰囲気 | 先輩・上司に気軽に質問ができる和気あいあいとした職場です。社員間の距離感を感じないくらい、人が温かく、仕事がしやすい職場です! |

施設見学に関して
いつでもご連絡をお待ちしています!
千葉県
 柏厚生総合病院
柏厚生総合病院
| 職員構成 | 合計43名(男性9名 女性34名) |
|---|---|
| 当直体制 | 当直 |
| 病理検査室の有無 | 有り |
| 職場の雰囲気 | 風通しがよく、若手が活躍しやすい活気ある職場です。 様々な領域の検査や知識の習得、多様な症例を経験できます。 |




施設見学に関して
随時お受けします。病院のホームページからお問い合わせください。
 津田沼中央総合病院
津田沼中央総合病院
| 職員構成 | 合計26名(男性7名 女性19名) |
|---|---|
| 当直体制 | 当直 |
| 病理検査室の有無 | 有り |
| 職場の雰囲気 | 担当部門にとらわれず幅広く検査に従事でき、コミュニケーションもとりやすい検査室です。 また、男女問わず育休・産休とりやすく、子育て世代も働きやすい環境になっています。 |




施設見学に関して
随時行っています。ホームページまたは病院人事課までご連絡下さい。
 船橋総合病院
船橋総合病院
| 職員構成 | 合計20名(男性6名 女性14名) |
|---|---|
| 当直体制 | 当直 |
| 病理検査室の有無 | なし |
| 職場の雰囲気 | 有給休暇や育休・産休など取りやすく、子育て世代も働きやすい環境です。 年齢関係なく、毎日会話や笑いの絶えないアットホームな検査室です。 |




施設見学に関して
随時見学可能です。ご希望の際は病院ホームページから是非お問い合わせ下さい。
 千葉愛友会記念病院
千葉愛友会記念病院
| 職員構成 | 合計18名(男性4名 女性14名) |
|---|---|
| 当直体制 | 当直 |
| 病理検査室の有無 | なし |
| 職場の雰囲気 | 幅広い業務に取り組むことができ、色々な知識や経験を積める病院です。 資格取得の際には、積極的なサポート体制が整っています。 |




施設見学に関して
随時見学可能です。ご希望の際は病院ホームページからお問い合わせ下さい。
神奈川県
 桜ヶ丘中央病院
桜ヶ丘中央病院
| 職員構成 | 合計12名(男性3名 女性9名) |
|---|---|
| 当直体制 | 当直 |
| 病理検査室の有無 | なし |
| 職場の雰囲気 | 中規模の病院の為、検体・生理検査どちらも携わる検査室です。 和気あいあいとした話しやすく、協力し合える環境となっています。 |




施設見学に関して
見学ご希望の場合は病院ホームページからお問い合わせください。
 金沢文庫病院
金沢文庫病院
| 職員構成 | 合計12名(男性3名 女性9名) |
|---|---|
| 当直体制 | 当直+オンコール |
| 病理検査室の有無 | なし |
| 職場の雰囲気 | 20~50歳代まで幅広い年齢層のスタッフが在籍し、アットホームな雰囲気です 院内・院外問わず研修会に参加し、資格取得を目指して日々の積み重ねを大切にしています |




施設見学に関して
随時見学可能です。ご希望の際には病院ホームページからお問合せください。
 横浜相原病院
横浜相原病院
| 職員構成 | 合計4名(男性1名 女性3名) |
|---|---|
| 当直体制 | オンコール |
| 病理検査室の有無 | なし |
| 職場の雰囲気 | 少人数の為コミュニケーションを大切しながら業務をしています。穏やかな職場です。 院内には部活動やイベントもあり、他部署との交流もあります。 |


施設見学に関して
随時見学可能です。
 さがみリハビリテーション病院
さがみリハビリテーション病院
| 職員構成 | 合計3名(男性0名 女性3名) |
|---|---|
| 当直体制 | オンコール |
| 病理検査室の有無 | なし |
| 職場の雰囲気 | リハビリテーション専門病院のこじんまりとした検査室です。検査技師も3名と少数のため和気あいあいとした雰囲気で、幅広い業務に対応しています。 |



施設見学に関して
随時見学可能です。ご希望の際は病院ホームページの採用情報からお問い合わせください。
 横浜なみきリハビリテーション病院
横浜なみきリハビリテーション病院
| 職員構成 | 合計6名(男性1名 女性5名) |
|---|---|
| 当直体制 | オンコール |
| 病理検査室の有無 | なし |
| 職場の雰囲気 | 落ち着いた雰囲気の職場です。健診、人間ドックに力を入れています。 |




施設見学に関して
随時可能。
 横浜鶴見リハビリテーション病院
横浜鶴見リハビリテーション病院
| 職員構成 | 合計4名(男性0名 女性4名) |
|---|---|
| 当直体制 | オンコール |
| 病理検査室の有無 | なし |
| 職場の雰囲気 | 穏やかな雰囲気の職場です。検査室と内科外来はバックヤードで繋がっているので、看護師さんとも仲が良いです。 |


施設見学に関して
見学可(2025.4.1現在)
東京都
 浅草病院
浅草病院
| 職員構成 | 合計12名(男性2名 女性10名) |
|---|---|
| 当直体制 | 当直 |
| 病理検査室の有無 | なし |
| 職場の雰囲気 | 検査科はどの診療科にも関わり、チーム医療の一員として迅速で正確なデータの提供に心がけています。検体検査から生理検査まで幅広く携わる地域密着型の病院です。 |




施設見学に関して
随時見学可能です。ホームページの「お問い合せ」よりお願いします。
 杉並リハビリテーション病院
杉並リハビリテーション病院
| 職員構成 | 合計3名(男性2名 女性1名) |
|---|---|
| 当直体制 | なし |
| 病理検査室の有無 | なし |
| 職場の雰囲気 | 和気あいあいの検査室です。 |


施設見学に関して
現在は行っていません。
茨城県
 勝田病院
勝田病院
| 職員構成 | 合計11名(男性4名 女性7名) |
|---|---|
| 当直体制 | 当直+オンコール |
| 病理検査室の有無 | なし |
| 職場の雰囲気 | 小さな検査室なのでスタッフ同士コミュニケーションを取り協力しながら全てのセクションの業務を行っています。働きやすく、気軽に何でも話せる検査室です。 |




施設見学に関して
随時見学可能です。ご希望の際は病院ホームページからお問い合わせ下さい。
山梨県
 笛吹中央病院
笛吹中央病院
| 職員構成 | 合計9名(男性1名 女性8名) |
|---|---|
| 当直体制 | 当直 |
| 病理検査室の有無 | なし |
| 職場の雰囲気 | 検体検査・生理検査の両方を幅広く経験することができます。先輩、後輩関係なく相談し合える職場です。チームワークを大切に、日々成長することができる環境です。 |




施設見学に関して
随時見学可能です。ご希望の際は病院ホームページからお問い合わせ下さい




